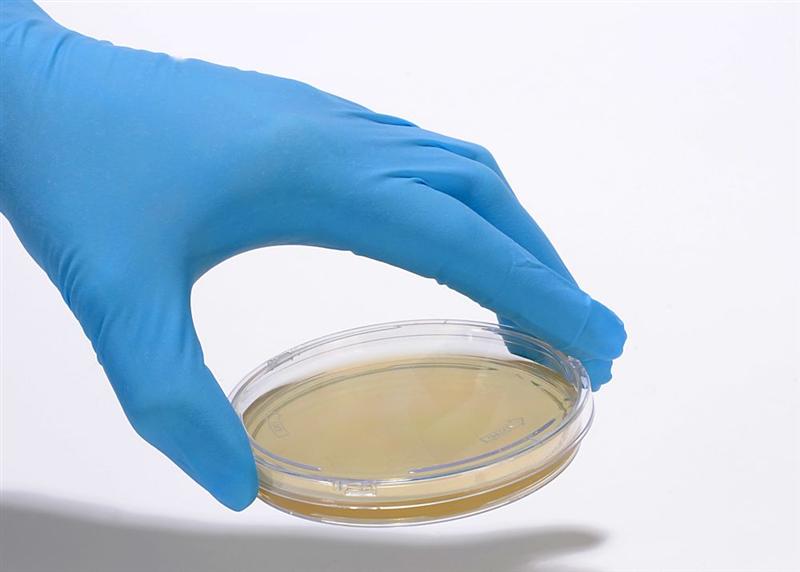
BioMerieux : bonne analyse ?

BioMerieux : bonne analyse ?
Ajustements en chaîne
BioMerieux reprend 0,5% à 110 euros ce mercredi après avoir affiché +7,3% de croissance organique des ventes sur les 9 premiers mois de l'année, parfaitement en ligne avec les objectifs annoncés, atteignant 2.992 millions d'euros, principalement grâce à une croissance organique de 9% des quatre moteurs de de croissance du plan stratégique GO-28.
Les objectifs 2025 ont été ajusté avec une croissance organique du chiffre d'affaires qui est désormais attendue entre +5,5% et +6,5% à taux de change constants (contre entre +6% et +7,5% précédemment) en raison d'une saison respiratoire tardive. Le groupe confirme une croissance attendue entre +12% et +18% du résultat opérationnel courant contributif (ROCC) à taux de change constants, sur la base d'une rentabilité à neuf mois pleinement en ligne avec la trajectoire GO-28. Les effets de change sont estimés avec un impact négatif de l'ordre de -30 millions d'euros sur le CEBIT annuel 2025, contre environ -25 millions d'euros précédemment...
Parmi les avis de brokers, Stifel a noté que bioMérieux avait publié des comptes du troisième trimestre inférieurs de 3% aux attentes en termes de chiffre d'affaires. Bien que ces résultats incluent une révision à la baisse de 50 à 100 points de base des prévisions de croissance du chiffre d'affaires et une diminution de 100 points de base du consensus, le maintien des prévisions de croissance de l'EBIT ajusté laisse présager que les estimations du BPA devraient rester stables, a expliqué le broker qui anticipe une première analyse très prudente du marché concernant les tendances liées à la saison respiratoire. Stifel reste à l'achat sur le dossier en visant un cours de 125 euros, tandis qu'AlphaValue accumule de son côté avec un objectif relevé à 135 euros. Enfin, Morgan Stanley est à 'pondération de marché' avec un objectif ramené de 120 à 113 euros.
Les informations et conseils rédigés par la rédaction de Boursier.com sont réalisés à partir des meilleures sources, même si la société Boursier.com ne peut en garantir l'exhaustivité ni la fiabilité. Ces contenus n'ont aucune valeur contractuelle et ne constituent en aucun cas une offre de vente ou une sollicitation d'achat de valeurs mobilières ou d'instruments financiers. La responsabilité de la société Boursier.com et/ou de ses dirigeants et salariés ne saurait être engagée en cas d'erreur, d'omission ou d'investissement inopportun.
- 0 vote
- 0 vote
- 0 vote
- 0 vote
- 0 vote














